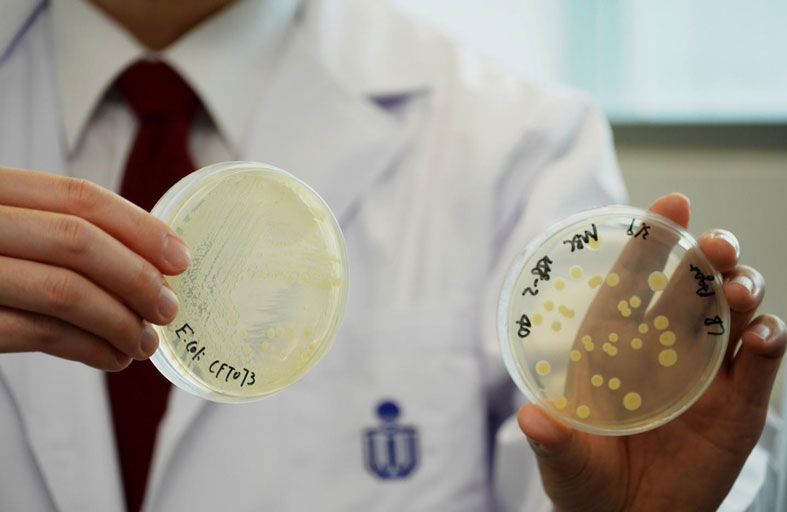

الألياف والماء والرياضة لحماية الأمعاء منها
«كوليباكتين».. بكتيريا معوية قد ترتبط بسرطان القولون
تشهد معدلات الإصابة بسرطان القولون والمستقيم ارتفاعاً لافتاً بين البالغين الأصغر سناً في الولايات المتحدة، ويرجح خبراء أن تكون صحة الأمعاء أحد العوامل الكامنة وراء ذلك.
وتوصل باحثون في كاليفورنيا إلى وجود صلة محتملة بين مادة سامة في الأمعاء تُعرف باسم "كوليباكتين" وارتفاع حالات السرطان لدى الأشخاص دون سن الـ50.
وتنتج الكوليباكتين أنواع ضارة من بكتيريا الأمعاء، من بينها الإشريكية القولونية، وهي من أكثر مسببات الأمراض المنقولة بالغذاء شيوعاً. ويمكن لهذا السم أن يلحق أذى بخلايا القولون، بما يؤدي إلى الإصابة بسرطان القولون والمستقيم الذي يُعد اليوم ثاني أكثر أسباب الوفاة بالسرطان شيوعاً في الولايات المتحدة.
وقال لودميل ألكسندروف، الأستاذ في جامعة كاليفورنيا في سان دييغو وعضو مركز موريس للسرطان التابع لها، ضمن بيان: "ليس كل عامل بيئي أو سلوك ندرسه يترك بصمة في جينومنا، لكننا وجدنا أن الكوليباكتين من بين العوامل القادرة على ذلك. وفي هذه الحالة، تبدو بصمته الجينية وثيقة الارتباط بسرطانات القولون والمستقيم لدى البالغين الأصغر سناً".
ووفقاً لجمعية السرطان الأميركية، من المتوقع تسجيل أكثر من 158 ألف إصابة جديدة بسرطان القولون والمستقيم و55 ألف وفاة هذا العام. لكن الخبراء يقولون إن هناك خطوات يمكن أن تساعد في الوقاية من الكوليباكتين الضار.
ويُعد فهم كيفية تأثير الكوليباكتين في الأمعاء خطوة أساسية في المواجهة، إذ تعيش في أمعاء الإنسان تريليونات من البكتيريا. وفي عمر ستة أشهر تكون الإشريكية القولونية شائعة جداً، لكن هذا يتغير مع التقدم في العمر.
وكان كريستيان جوبين، الباحث في شؤون الميكروبيوم بجامعة فلوريدا، قال سابقاً لإذاعة "أن بي آر" إن نحو 20 إلى 30 في المئة من البالغين يحملون سلالات من الإشريكية القولونية قادرة على إنتاج الكوليباكتين. لكن ليس كل من يحمل هذه السلالات يصاب بسرطان القولون والمستقيم، كما أن السرطان المرتبط بالكوليباكتين أقل شيوعاً في أفريقيا وآسيا منه في الولايات المتحدة وأوروبا الغربية.
ولا يزال الباحثون يجهلون السبب الدقيق لذلك، غير أن جوبين قال إن "بعض سلالات الإشريكية القولونية المنتجة للكوليباكتين تتأثر بالنظام الغذائي والالتهابات والأدوية".
ورجّح أن تكون طريقة الولادة والرضاعة الطبيعية واستخدام المضادات الحيوية وتناول الأطفال أطعمة فائقة المعالجة، كلها عوامل محتملة.
وأضاف: "من المعروف أن هذه العوامل كلها تؤثر بقوة في الميكروبيوم، وهناك بعض الأدلة على أنها قد تؤثر في هذه البكتيريا (المنتجة للكوليباكتين)، لكننا بحاجة إلى دراسة كل عامل منها بعناية".
وأشار باحثون في جامعة كاليفورنيا في سان دييغو إلى أن كثيراً من أنواع السرطان قد ينشأ عن تعرضات ميكروبية أو بيئية تسبق تشخيص الإصابة بسرطان القولون والمستقيم بوقت طويل.
وقال ألكسندروف: "من الممكن ألا يقتصر الأمر على ما يحدث في مرحلة البلوغ، بل من المحتمل أن يتأثر السرطان بأحداث تقع في مراحل مبكرة من الحياة، وربما حتى خلال الأعوام الأولى".
وبالنسبة إلى الرضع، تُعد صحة الأمعاء أمراً أساسياً لسلامة الجهاز العصبي والمناعي والهضمي. وتُعد الأسابيع والأشهر الأولى من الحياة "حاسمة"، وفقاً لمؤسسة "تشيلدرنز هيلث كير أسوشييتس" في شيكاغو.
ويمكن للوالدين دعم صحة أمعاء أطفالهم من خلال الرضاعة الطبيعية، وتقديم أطعمة غنية بالبكتيريا المفيدة، واستخدام حليب صناعي مدعّم ببروبيوتيك يساعد في توازن الأمعاء، وتوفير الملامسة الجلدية المباشرة للرضع. فحليب الأم غني بالبكتيريا النافعة، كما أن البكتيريا الموجودة على الجلد يمكن أن تنتقل إلى الرضع، مما يساعد في بناء أمعاء صحية.
ومن المهم أيضاً تجنب إعطاء الرضع مضادات حيوية غير ضرورية.
ووفقاً لمؤسسة "ستانفورد ميديسن": "يمكن للمضادات الحيوية أن تقضي على التهاب أذن حاد وتعالج التهاب الحلق العقدي، لكنها قد تقتل أيضاً بكتيريا الأمعاء النافعة في الوقت نفسه. لذلك لا ينبغي استخدام هذه الأدوية إلا عند الضرورة، وليس لعلاج العدوى الفيروسية مثل نزلات البرد والإنفلونزا وكثير من التهابات الأذن والجيوب الأنفية".
أما بالنسبة إلى البالغين، فالنصيحة متقاربة إلى حد كبير. فمجرد تناول حصة واحدة من الأطعمة الغنية بالبروبيوتيك مثل الزبادي والمخللات ومخلل الملفوف وخبز العجين المخمر، قد يساعد في رفع مستويات البكتيريا النافعة في الأمعاء، والحد من البكتيريا الضارة عبر إنتاج الأحماض، وفقاً لمستشفى الأطفال في فيلادلفيا. كذلك تساعد هذه الأطعمة في مقاومة الالتهابات الضارة التي تقف وراء أمراض مزمنة مثل السرطان.
وإضافة كميات وفيرة من الألياف التي تساعد في مكافحة الالتهاب إلى النظام الغذائي اليومي أمر مفيد أيضاً. فالأطعمة الغنية بالألياف مثل الفلفل الحلو والموز والشوفان والهليون، تعمل عمل البروبيوتيك، أي الغذاء الذي يغذي البكتيريا النافعة في الأمعاء. ومن الممكن أن تساعد الألياف في الوقاية من طيف من البكتيريا الضارة، بما في ذلك الإشريكية القولونية، وفقاً لباحثين في جامعة "كامبريدج" البريطانية.
ووفقاً لـ"مركز لوبوك لأمراض الجهاز الهضمي" في تكساس، فإن الحصول على ثلاثة إلى خمسة غرامات فقط من البريبايوتيك يومياً ثبتت فائدته لصحة الأمعاء.
وفي السياق نفسه، فإن الحفاظ على ترطيب الجسم والبقاء نشطاً يساعدان في الوقاية من الإمساك، ويتركان أيضاً أثراً إيجابياً في ميكروبيوم الأمعاء، بحسب "هارفارد هيلث".
وأظهرت دراسة أُجريت في إسبانيا عام 2017 أن الأشخاص الذين يتبعون نمط حياة قليل الحركة يملكون عدداً أقل من أنواع البكتيريا المرتبطة بتحسين الصحة. لكن 150 دقيقة من التمارين المعتدلة أسبوعياً، وهي المدة الموصى بها اتحادياً في الولايات المتحدة، تكفي لإحداث أثر إيجابي في صحة الأمعاء، وفقاً لبحث أسترالي نشر عام 2023.
وتشير "جامعة هارفارد" إلى أن شرب الماء يساعد في إنتاج الطبقة المخاطية التي تحمي الجهاز الهضمي. وتوصي "مايو كلينك" بأن تشرب النساء نحو 11.5 كوباً، سعة كل منها ثماني أونصات، يومياً، مقابل 15.5 كوباً للرجال.
وأظهرت دراسة أجرتها "جامعة تورنتو" العام الماضي أن الفئران التي اتبعت أنظمة غذائية منخفضة الكربوهيدرات كانت لديها طبقات مخاطية أرق، مما أتاح لكمية أكبر من الكوليباكتين الوصول إلى خلايا القولون.
في المقابل، أدى تناول الألياف إلى خفض مستويات الإشريكية القولونية وتقليل تلف الحمض النووي. وقال الباحث في مرحلة بعد الدكتوراه بوبيش ثاكور: "نحاول الآن معرفة أية مصادر الألياف أكثر فائدة، وأيها أقل فائدة".